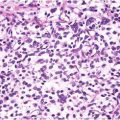

Fig. 72.1
Cutaneous metastases from gastric carcinoma. An erythematous plaque around a scar from excision of a primary neoplasm

Fig. 72.2
Cutaneous metastases from colon adenocarcinoma. Sister Mary Joseph’s periumbilical nodules
Classically, gastric cancers have been associated with umbilical nodules (so-called Sister Joseph nodules). These are named after the surgical assistant of St. Mary’s Hospital at the Mayo Clinic, Sister Mary Joseph, who first noticed the development of an indurated umbilical nodule in the setting of gastric cancer. However, these umbilical metastases may come from tumors other than the stomach, like ovary, colon, rectum, or pancreas. The primary site remains unknown in almost 30 % of cases. The mechanisms of metastasis include contiguous infiltration and spread via the blood or lymphatic vessels.
Skin metastases from oral cavity cancers are almost always squamous cell carcinomas. They usually occur in men and arise at the site of surgery for the primary tumor. Apart from the head and neck region, they may appear at remote sites like back or elbow. They usually present as multiple nodules, but they can also appear as ulcers. As they usually appear on the head and neck region, differentiation from primary cutaneous squamous cell carcinoma can be very difficult.
Cutaneous metastases from esophageal cancer are extremely rare. Most reported esophageal cancers were squamous cell carcinoma, but there were some case reports of skin metastases from esophageal adenocarcinoma. As with other internal cancers, cutaneous metastases from esophageal cancer may present as solitary or widespread nodules. Reported sites of involvement include scalp, finger, and axilla.
Pathology
Histologically, skin metastases from colorectal carcinoma tend to present with well-differentiated, often mucin-secreting, glandular structures (Figs. 72.3 and 72.4). Sometimes, due to abundant mucin secretion, a mucinous carcinoma-like pattern may be encountered. Other histological variants include: papillary, signet-ring cell, adenoid cystic, and anaplastic variants. Carcinoids may show different histological patterns depending on the original site of the tumor: trabecular pattern is usually associated with stomach carcinoids, nodular pattern is associated with carcinoids originating in the small intestine, and proximal colon and mixed pattern with the distal colon and rectum carcinoids. Some metastases may display a pronounced epidermotropism.


Fig. 72.3
Cutaneous metastases from colon adenocarcinoma (Sister Mary Joseph’s nodule). Infiltrating atypical glandular structures